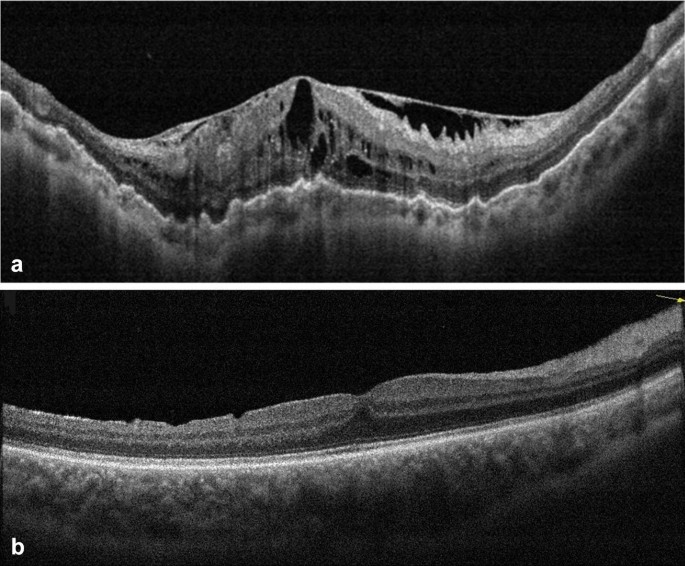

[ベスト] scp-1121 322761-Scp-1121-ru
Miranda was awarded a Pick Hit for its Densité SCP1121 SDI control probe Programmable panels are also becoming more economical to produce, allowing a 16×1 panel to be programmed for use as two 8×1s, four 4×1s or even eight 2×1sThis Secondary SCP BioContainment is located near a small island in , holds the only known instance of SCP1121, and it's specimens TO BE ADDED Offices Possibly 'Butt Ghost' SCP1121 (I currently have it's containment cell) My Own OfficeSCP2230 SCP2229 SCP2228 SCP2227 SCP2226 SCP2225 SCP2224 SCP2223 SCP2222 SCP2221 SCP22 SCP2219 SCP2218 SCP2217 SCP2216 SCP2215 SCP2214 SCP2213 SCP2212 SCP2211 SCP2210 SCP29 SCP28 SCP27 SCP26 SCP25 SCP24 SCP23 SCP22 SCP21 SCP SCP2199 SCP2198 SCP2197 SCP2196 SCP

Miranda Grass Valley Icontrol Server Ic Base Edition V2 V6 03 0448 00 118 Ebay
Scp-1121-ru
Scp-1121-ru-Descripción SCP1121 es un protozoo ameboide previamente desconocido con cualidades mutagénicas muy específicas desencadenadas solo por Staphylococcus epidermidis, una bacteria normalmente benigna presente en la piel humanaSi se introduce en otros organismos, SCP1121 permanece inactivo El ADN extraído de las muestras de SCP1121 comparte genes con varias · Info Object Class Safe Animate?



Uboubz7v1wfenm
Addendum 112 Tests involving D1732 showed that he could encounter the entity in bodies of water that would usually be insufficient for its containment The effect became more drastic over time The subject could see SCP 11 outside almost any body of water On / / , D1732 was violently pulled into a glass of water by REDACTEDSCP1126 Agent Palmer;76 FRS1801 Hd CONVERSION & PROCESSING The FRS1801 is a highly integrated module which offers frame synchronization, and video processing, including color correction and
SCP1121 SDI control probe with embedded audio The awardwinning SCP1121 is a nonintrusive probe for the quality control of SDI (SMPTE 259MC) digital video signals with embedded SMPTE 272M digital audio The SCP1121 probe integrates several advanced features for monitoring both video and embedded audio signals"Baby's First Guide to EuclidClass Anomalies" & Other Questionable Documents Recovered from the Hard Drive of Dr Captain Kirby's Proposal DjoricDmatix Proposal Dr Clef's Proposal Dr Mackenzie's Proposal Eberstrom's ProposalARC SCP𝕐 SCPSCP1221 are Keterclassed humanoidcreatures from the SCP Foundation SCP1221 appear to be humanoidcreatures which are totally blackcolored If any shadows are seen on SCP122, translucent mass would get released out of the SCP 1 History 11 Incident 1221 2 Trivia 3 Navigation SCP1221 is located in a chamber, with SCP122, which is a children's nightlight SCP
Grant of letters to others If any eligible distributee of the decedent shall petition to supersede the public administrator within 4 months after the public administrator has become vested with the powers of a fiduciary on the estate letters shall be granted to him upon proof that the petitioner did not receive notice of the application by the public administrator and upon the further showingThis is another episode of my 'spinoff' series for Adventures at Site19 In this series I'll be making short viSCP1132 Snake Tongue;



Frontiers Immune Evasion Strategies Of Schistosomes Immunology



Soild Phase Synthesis Of Mgal2o4 Powder In Reducing Atmosphere Effects Of Alumina Sources And Addition Of Carbon Black Iopscience
Description You can be a SCP subject or be one of the staff members of the containment facility and roleplay in different chat roomsHardcore After Effects courses online from best authors around the world Get started learning Adobe After Effects for free today!261 261 densité modular products distribution and monitoring # projet sda1102srp sda1102drp sda1142srp sda1142drp sdm1151drp scp1121srp/l msb1121srp adx1101drp adxsrp adxsrp adxdrp adxdrp amx1101drp amxsrp amxsrp amxdrp amxdrp enc1101srp enc1101drp enc1103srp enc1103


Scp 1121 The Skinning Disease Scp Secure Contain Protect



Mtpn6fiz9jyrm
0912 · SCP1121 Tx test SCP1121 Tx test euclid;これは、scp1121jpにおいて発見された、手紙と思われるメモの全文です。 scp1121jp関連文章01 発見日付 / / 拝啓 ようやく寒さも緩み、おだやかな陽気が続く中、いかがお過ごしでしょうか?SCP1121 is a previously unknown amoeboid protozoa with very specific mutagenic qualities triggered only by Staphylococcus epidermidis, a normally benign bacterium present on human skin If introduced to other organisms, SCP1121 remains dormant



Image Archive


Albom Dzho Dunkana The Scp Foundation
No SCP Link SCP1123This SCP has music relating to it Containment Chamber SCP1123, or "Atrocity Skull", is an SCP object encountered in SCP Containment Breach 1 Description 2 Ingame 3 Quotes 4 Gallery SCP1123 is a human skull missing the lower mandible and all its teeth When a subject touches the surface ofSCP1121 The Skinning Disease;Get ready to meet SCP11!



Structural Imaging In Atypical Parkinsonism Sciencedirect



琴峠りな クロトゲ 創作 黄泉の鏡原稿がんばるぞ على تويتر 参考 Author Kyougoku08 Title Scp 1121 Jp 廃墟の街 Source T Co 34xcd2hcpf Author Me Te De Ko Title Scp 544 Jp 孤独な放送室 Source T Co Srea3otdvn Author
SCP372 is to be contained in a cell, 5m x 4m x 2m, lined with reinforced plexiglass Embedded intoSCP1121 The Skinning Disease SCP1122 The House of Tomorrow SCP1123 Atrocity Skull SCP1124 Xenoplague SCP1125 Answer Dice SCP1126 Agent Palmer SCP1127 A Film Festival SCP1128 Aquatic Horror SCP1129 Hyperarousal Response SCP1130 A Handy Shortcut SCP1131 The Oscar Bug SCP1132 Snake Tongue SCP1133Read this complete New York Consolidated Laws, Surrogate's Court Procedure Act SCP § 1121 Grant of letters to others on Westlaw FindLaw Codes are provided courtesy of Thomson Reuters Westlaw, the industryleading online legal research system For more detailed codes research information, including annotations and citations, please visit Westlaw



ゆっくり解説 Scp 1121 Jp 廃墟の街 Youtube


Scp Foundation Crayne S Author Page
Объект № scp1121ru Класс объекта Безопасный Не назначен, ожидается реклассификация Особые условия содержания Каждый образец scp должен содержаться в герметичном металлическом контейнере Все контейнерыSCP began Classified Subject D6874, korean male, age 28, height 5'8 D6874 was given one 125 watt searchlight, 40 feet of rope, custom coltCan you name the SCPs from ?



Brand New Sony Never Used Rfu Adaptor Scph 1121 For Sony Playstation Ps1 Ebay



The Lowest Mean Supercooling Point Scp Observed For Adult Harmonia Download Scientific Diagram
Bio Site13 A secondary biocontainment facility, currently holding the only known specimens of SCP1121 Research Site14 Main radiation research location Objects include SCP081, SCP113 when being researched, and SCP578 Site15 Mainly a storage facility for electronic SCPs · 478k members in the SCP community Secure, Contain, Protect The official subreddit of the SCP Wiki collaborativefiction project on scpwikicomFree delivery for many products!


Scp Foundation Crayne S Author Page



Jokerlives Tumblr Com Tumbex
SCP1130 A Handy Shortcut;Miranda Densite 2 Chassis 23 Cards ACP1721 HCO1121 VCP1021 SCP1121 ADX1121 $ Brand Miranda $7840 shipping nderaa 4290 Ocean Current Profiler Doppler Sensor (ADCP Xylem SonTek Teledyne) $ $4500 shipping 15 watching 30HP Reliance GV3000 AC Drive 3PH 380/460 VAC MOD# 30V4150 w/ Starter BoxSCP1131 The Oscar Bug;



Cerebral Circulation During Retrograde Cerebral Perfusion Evaluation Using Laser Speckle Flowgraphy The Annals Of Thoracic Surgery



Was Made Wy Seapeasen Made To The Was Ied By With Was Covives By Scp Riea By Ifunny
· SCP1121 is a previously unknown amoeboid protozoa with very specific mutagenic qualities triggered only by Staphylococcus epidermidis, a normally benignSCP1123 Atrocity Skull;Hardcore motion design courses online from best authors around the world Get started learning motion graphic design for free today!



Scp 1121 Wiki Scp Subject Amino Amino



Scp Infection Page 1 Line 17qq Com
SCP1122 is an abandoned tourist attraction located on the outskirts of , It was originally constructed in 195 as a "house of tomorrow", a demonstration of the thenfuturistic technologies expected to become commonplace over the following twentyfive yearsรายละเอียด SCP1122 เป็นจุดท่องเที่ยวร้างซึ่งอยู่นอกเมือง , มันได้รับการก่อสร้างเมื่อปี 195 ในฐานะ "บ้านแห่งวันพรุ่งนี้" ซึ่งเป็นการจัดแสดงวิทยาการในอนาคตของตอนนั้นซึ่งคาดว่าจะSCP122, also known as "No More Monsters", is a Keterclass object contained within SCP Foundation's containment As strange it may sound, SCP122 is a child's nightlight, designed to look like a star This product is unregistered, has no brand name written anywhere on the structure So, it is safe to presume this nightlight is all but normal in its kind Reports indicates that when it is in



Scp 1106 Page 1 Line 17qq Com



Scp 11 Freeze Scp Secure Contain Protect
SCP1121 was discovered on a meteorite unearthed during an archeological dig in , New Mexico in 19 The archeologist first exposed to the meteorite was infected with SCP and is at this point considered to be patient zeroItem # SCP1123 Object Class Safe Special Containment Procedures To prevent degradation of SCP1123 and its markings, it is to be kept in a hermetically sealed container in an argon gas atmosphere when not being tested During testing and storage, light exposure should be limited to 50 lux, temperature between and 24 degrees Celsius, and relative humidity at 55%DEC1023 Sd CONVERSION & PROCESSING DEC1023 12Bit 3D Composite to SDI Decoder with Probing The DEC1023 is a highquality composite analog video to SDI decoder



Scp 035 Scp 049 Friday Night Funkin Skin Mods



Scp 1121 Jp 廃墟の街 Scptcgjpj Wiki Fandom
De nieuwste tweets van @exvs2_kusoData rates achievable with SMPSCPULA confirming to 65 IEEEn standards with 40 MHz bandwith for 4 4 and 6 6 array configurations are 300 and 4 Mbits/s, SMP−SCP−1141 respectively, for 0 angular spreads that are much more 6 SMP−SCP−2131 SMP−SCP−3141 higher than standard 125 Mbits/s data rate achievable with SMP−SCP−2141 SMP−SCP−1121 SISO"SCP" stands for "Special Containment Procedures" (with the backronym motto of "Secure, Contain, Protect") which sums up both the goals and methods of the Foundation's supposed actionsSupplementary information includes short stories, profiles of "researchers" (authors), and an associated IRC chat room Roleplay is strongly discouraged on the main site, to the extent of



Historic New Redmond Hotel Reopens Dec 6 After 2 Year Renovation Ktvz



Tuning By Analogy Versus Calibra P I Scpso Results Download Scientific Diagram
SCP1128 Aquatic Horror;SCP1129 Hyperarousal Response;SCP1122 The House of Tomorrow;



Comparative Study Of The Antennal Phenotype In Species Of The Belminus Hemiptera Triatominae Genus Using Optical And Scanning Electron Microscopy



Study Of Lrrk2 Variation In Tauopathy Progressive Supranuclear Palsy And Corticobasal Degeneration Sanchez Contreras 17 Movement Disorders Wiley Online Library
Visits 21 SCP Bio Site13 Read Desc UPDATE I have abandoned this place again, yay!SCP1127 A Film Festival; · SCP 1121 A·l1 0601 25 gallons us Standard Measure KEEP OUT OF REACH OF CHILDREN CAUTION fiRST AID If in eyes I Flush eyes with plenty of water Call a physician if irritation persists Have the product container or label with you when calling a poison control center or doctor, or going for treatment HOT LINE NUMBER



Aphids True Hoppers Jumping Plant Lice Scale Insects True Bugs And Whiteflies Insecta Hemiptera From The Insect Limestone Latest Eocene Of The Isle Of Wight Uk Earth And Environmental Science Transactions Of



Comparative Study Of The Antennal Phenotype In Species Of The Belminus Hemiptera Triatominae Genus Using Optical And Scanning Electron Microscopy
Find many great new & used options and get the best deals for Miranda Densite SCP1121 with back plate tested working at the best online prices at eBay!By 8Dustin, December 8, in Archive Share Followers 0 Start new topic;The SCP1121 probe integrates several advanced features for monitoring both video and embedded audio signals Miranda Densite Chassis (5) ADA1021 (1) ADX11 (2) SCP1121 (1) ADX1121 eBay Skip to main content


Xenomorph666 S Scp Pixel Sprite Art Gallary Scp Foundation



Scp 1121 The Skinning Disease Scp Secure Contain Protect
Company (US) Pools & Spas SCP Manufacturer PENTAIR WATER POOL AND SPA INC Product Number PAC Manufacturer Part # 1592 UOM EAAn Archive of Our Own, a project of the Organization for Transformative WorksCurrently holding the only known specimens of SCP1121 Research Site14 Main radiation research location Objects include SCP081, SCP113 when being researched, and SCP578 Site15 Mainly a storage facility for electronic SCPs Currently contains SCP079 amongst other archives and databases Use of internet and other connections is



Evaluation Of Primary Internal Limiting Membrane Peeling In Cases With Rhegmatogenous Retinal Detachment International Journal Of Retina And Vitreous Full Text



Multiscale Design Of A Dairy Beverage Model Composed Of Candida Utilis Single Cell Protein Supplemented With Oleic Acid Journal Of Dairy Science
19k votes, 237 comments 465k members in the SCP community Secure, Contain, Protect The official subreddit for the SCP WikiSCP1125 Answer Dice;



Scp 1121 Wiki Scp Subject Amino Amino



A Mutation In The Intron Splice Acceptor Site Of A Ga3ox Gene Confers Dwarf Architecture In Watermelon Citrullus Lanatus L Scientific Reports


Scp 1121 Scp Sandbox Wiki I



Underwater Sound Radiation From An Elastically Coated Plate With An Embedded And Distributed Inhomogeneity The Journal Of The Acoustical Society Of America Vol 137 No 5


Scp Foundation Crayne S Author Page



Scp The Lawrence Houseworth Albums



Pin On Electriccrimson



Scp Readings Scp 1155 Predatory Street Art Youtube



Uboubz7v1wfenm



Scp 1121 Youtube



Penny Fitzgerald Meets Scp 173 By Jumpscarez On Deviantart



Underwater Sound Radiation From An Elastically Coated Plate With A Discontinuity Introduced By A Signal Conditioning Plate The Journal Of The Acoustical Society Of America Vol 133 No 1


Image Review 12 Scp Sandbox Wiki Ii



Scp 610 Symptoms Page 1 Line 17qq Com



Scp 1121 Showit Blog



Scp 1127 Page 4 Line 17qq Com



Scp 1106 Page 1 Line 17qq Com


Scp Foundation Crayne S Author Page



Spectral And Power Efficiency Of Ieee802 11n Mimo Ofdm Wlan Systems Using Space Multimode Polarization Diversity Compact Stacked Circular Microstrip Antenna Arrays Yavanoglu 11 European Transactions On Telecommunications Wiley Online Library



Huntington S Disease Hd The Neuropathology Of A Multisystem Neurodegenerative Disorder Of The Human Brain Rub 16 Brain Pathology Wiley Online Library



Kazumikkusu Scpに合いそうな曲を考える Scp 1121 Jp 曲名 シャルル



Jakiego Scp Wolisz Samequizy



Miranda Grass Valley Icontrol Server Ic Base Edition V2 V6 03 0448 00 118 Ebay



Scp 1145 Page 1 Line 17qq Com


Scp 999 Scp Subject Amino Amino



173 096 Scp Foundation Amino



Scp 999 Scp Subject Amino Amino



Comparative Study Of The Antennal Phenotype In Species Of The Belminus Hemiptera Triatominae Genus Using Optical And Scanning Electron Microscopy


Scp Foundation Crayne S Author Page



Scp 5760 Page 1 Line 17qq Com

Evaluation Of Primary Internal Limiting Membrane Peeling In Cases With Rhegmatogenous Retinal Detachment International Journal Of Retina And Vitreous Full Text



Scp 156 Faire Com



Pdf On The Design And Performance Analysis Of Low Correlation Compact Space Multimode Diversity Stacked Microstrip Antenna Arrays For Mimo Ofdm Wlans Over Statistically Clustered Indoor Radio Channels Semantic Scholar



Hey Guys I M New To Scp S And All That And I M Very Very Interested What Scp S Should I Tackle Any Recommendations Scp


Albom Dzho Dunkana The Scp Foundation



Pharmaceutics Free Full Text Evaluation Of Direct And Cell Mediated Lactoferrin Gene Therapy For The Maxillofacial Area Abscesses In Rats Html



Skin Don T Do That Let S Read The Scp Foundation Wiki 225 Youtube



Look At This Adorable Little Starfish My Friend Found Aww



The Orbitofrontal Cortex Projects To The Parvafox Nucleus Of The Ventrolateral Hypothalamus And To Its Targets In The Ventromedial Periaqueductal Grey Matter Springerlink


Crayne S Author Page Scp Foundation



Scp 1171 By Vinevin On Deviantart



Miranda Densite Chassis W 8 X Frs 1101 8 X Adx 1141 1 X Msb 1121 494 99 Picclick


How Would The Scp Foundation Deal With Asriel Dreemurr Quora


Scp 1121 박피병 네이버 블로그


Scp 1121 Wiki Scp Subject Amino Amino


Scp 1121 Scp Foundation



Scanning Electron Image Of Scp 1121 1 Description Scp 1121 Is A Previously Unknown Amoeboid Protozoa With Very Specific Mutagenic Qualities Triggered Only By Staphylococcus Epidermidis A Normally Benign Bacterium Present On Human Skin If


Image Review 12 Scp Sandbox Wiki Ii



The Scp Foundation Scp Series Genius



Scp 5067 Faire Com


Scp 610 Wiki Scp Subject Amino Amino



Identification Of Mesenchymal Stromal Cells In Human Lung Parenchyma Capable Of Differentiating Into Aquaporin 5 Expressing Cells Laboratory Investigation



Here We See Scp 049 T Posing To Show Its Dominance Over The Other Scp S Isnt This A Spectacular Sight To See Dankmemesfromsite19



Scp 1121 Amyoba Shkurodyor Staraya Ozvuchka Youtube


Association Of High Risk Neuroblastoma Classification Based On Expression Profiles With Differentiation And Metabolism



Server Suggestion Scp Rp



Image Archive



Cells Free Full Text In Vitro Generation Of Oocyte Like Cells And Their In Vivo Efficacy How Far We Have Been Succeeded Html



Mtpn6fiz9jyrm



Underwater Sound Radiation From An Elastically Coated Plate With A Discontinuity Introduced By A Signal Conditioning Plate The Journal Of The Acoustical Society Of America Vol 133 No 1



Scp 610 Infection Page 1 Line 17qq Com


コメント
コメントを投稿